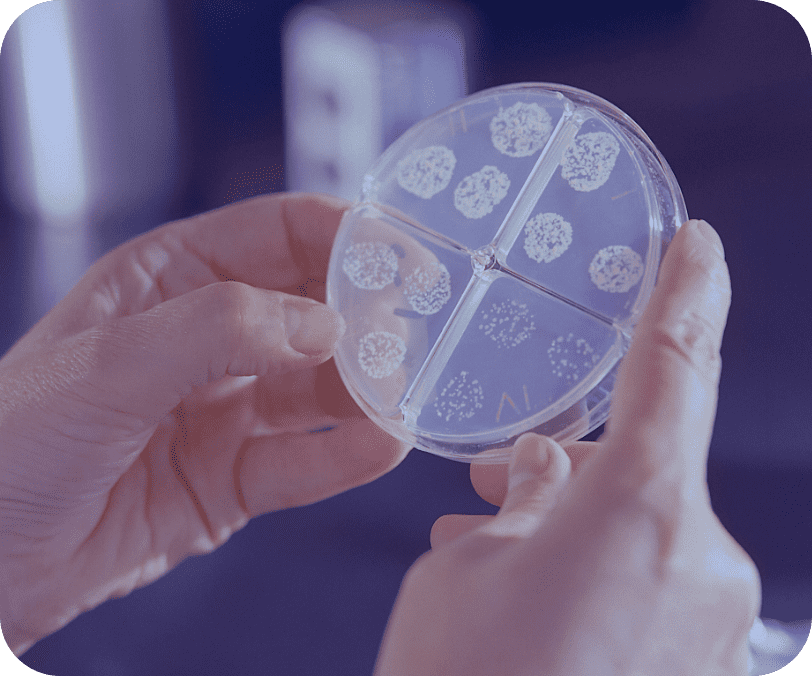
banner1

Sustainability as the core
At the core of our large-scale manufacturing strategy lies cutting-edge technology aimed at minimizing environmental impact and maximizing operational efficiency. Leveraging continuous flow processing technology, we streamline manufacturing processes to significantly reduce our footprint while optimizing space and resource utilization. Automation is intelligently integrated into our shop floor operations, driving efficiency gains and minimizing manual intervention. Our commitment to technological innovation extends to energy management systems and energy-efficient practices, enabling us to drastically reduce energy consumption across our operations. Through the seamless integration of sustainable technologies and eco-conscious practices, we actively mitigate our environmental impact, promoting responsible manufacturing while meeting the demands of a modern, sustainable industry.

Streamlined
Manufacturing Footprint
Employing continuous flow processing techniques to minimize the manufacturing footprint, particularly for large-scale production.
Implementing lean principles and efficient layouts to optimize space utilization and reduce waste in the manufacturing environment.
Enhanced Shop
Floor Efficiencies
Embracing automation technologies to improve efficiencies on the shop floor, streamlining processes and enhancing productivity.
Utilizing smart manufacturing solutions and real-time monitoring systems to identify bottlenecks and optimize production flows.


Energy
Consumption Reduction
Implementing energy-efficient practices and technologies to reduce overall energy consumption across manufacturing operations.
Incorporating renewable energy sources and energy management systems to minimize reliance on traditional energy sources and lower carbon emissions.
Environmental
Impact Mitigation
Integrating sustainable practices throughout the production process to minimize environmental load and promote eco-friendly manufacturing.
Adopting eco-conscious materials, waste reduction strategies, and recycling programs to lessen the overall environmental footprint of operations.